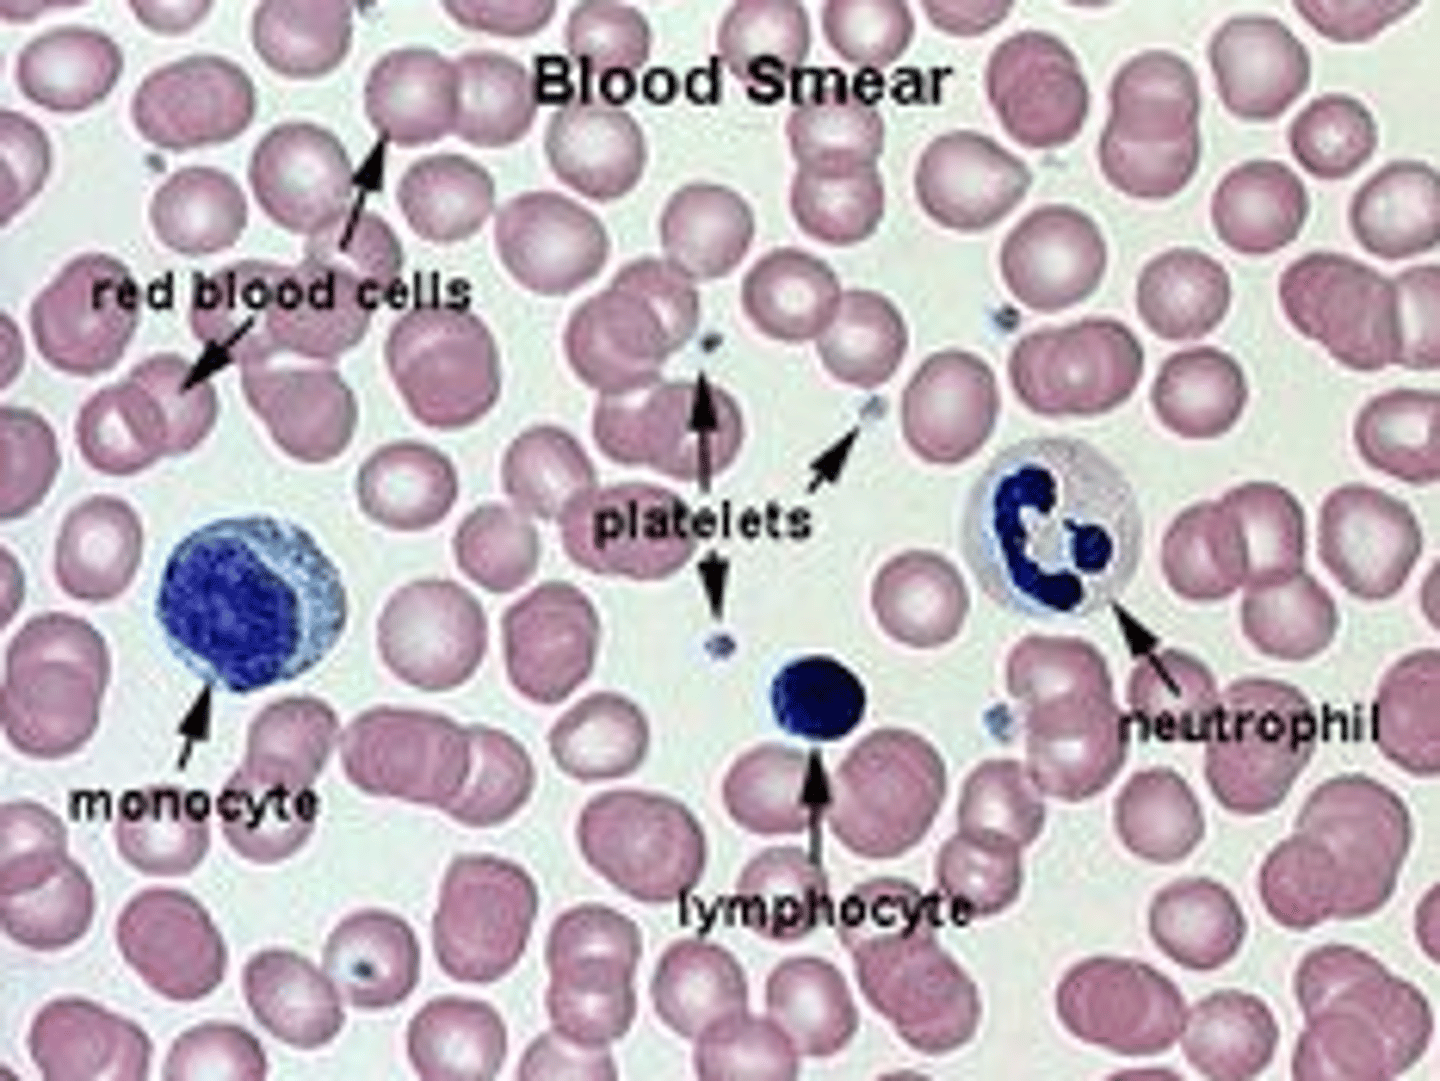
knowt flashcard image

Bio 1031 Final - Auburn University
1/105
There's no tags or description
Looks like no tags are added yet.
Name | Mastery | Learn | Test | Matching | Spaced | Call with Kai |
|---|
No analytics yet
Send a link to your students to track their progress
106 Terms
Phylum Porifera
"pore bearers", most asymmetric, no true tissues, multicellular, have internal skeletons, mostly sessile (non-motile), reproduce sexually and/or assexually.

Sponge types in increasing complexity
Asconoid, Syconoid, Leuconoid

Phylum Ctenophora
Comb Jellies

Phylum Cnidaria
Have true tissues, radial symmetry, cnidocytes, sessile (non-motile) or planktonic (limited locomotion), polyp (sessile) -> medusa (motile)

Phylum Cnidaria: Class Hydrozoa
Hydroids, solitary or colonial polyps, can have polyps and medusae in life cycle

Phylum Cnidaria: Class Scyphozoa
Jellyfish, solitary and large medusae, polyps either reduced or completely absent in life cycle

Phylum Cnidaria: Class Anthozoa
Sea anemones and corals, solitary or colonial polyps, no medusae in life cycle

Obelia spp.
Class Hydrozoa, colonial marine organism.

Portuguese Man-o-War
Colonial, Both polyps and medusae in a colony have superficial resemblance to just a large medusa!

Bilateria: Acoelomates
No body cavity

Bilateria: Pseudocoelomates
Body cavity bound by mesoderm on one side, endoderm on the other

Bilateria: Coelomates (eucoelomates)
Body cavity surrounded by mesoderm only on both sides

Bilateria: Protostomia
"Mouth first", the mouth forms from the blastopore.
Bilateria: Deuterostomia
"Mouth second", the anus forms from the blastopore, humans are deuterostomes
Phylum Platyhelminthes
Bilateria, flatworms, Acoelomate, Dorsoventral flattening, most are parasitic, hermaphroditic.

Phylum Annelida
Segmented worms (Annelid = segmented), use coelem for hydrostatic skeleton (flexible skeleton made of fluid-filled compartments), closed circulatory system, most have setae (chitinous bristles)

Platyhelminthes Classes
Class Turbellaria - planarians, Class Cestoda - tapeworms, Class Trematoda - flukes

Annelida Classes
Class Polychata - polychaetes (many hairs), Class Oligochatea - earthworms (oligo = few), Class Hirudinea - leeches

Clamworm
Phylum Annelida, Class Polychaeta, distinct head with tentacles, eyes, and jaws, fleshy parapodia on segments

Earthworm
Phylum Annelida, Class Oligochaeta, has Clitellum (band used in mating)

Leech
Phylum Annelida, Class Hirudinea

Phylum Mollusca
2nd most diverse phylum of animals, Unsegmented, Coelomate, Complete digestive system, muscular foot, mantle, most have a radula (rasping tongue with chitinous teeth)

Mollusca Classes
Class Polyplacophora (chitons),
Class Gastropoda (gastropods (snails, slugs)),
Class Bivalvia (bivalves (scallops, oysters),
Class Cephalopoda (cephalopods (octopuses, squid))

Ecdysozoa
Supergroup of protostomes; characterized by periodic molting (ecdysis) of their exoskeleton (cuticle). Include the roundworms and arthropods.

Phylum Nematoda
Roundworms, Ecdysis - periodic shedding of cuticle (energetically expensive/costly and actually prevents growth), pseudocoelomate, dioecious (male/female parts in seperate individuals), longitudinal muscles, many free living, many parasites.

C. elegans
Free-living, transparent nematode. 1mm long in soil.

Ascaris
Genus of roundworm parasites that live in the intestines of pigs, horses, and humans

Vinegar Eels
Phylum Nematoda

Ascaris (roundworm) cross section
(cuticle is outer skin)

Class Arachnida
Arthropoda, chelicerae with fangs, pedipalps (used by males in mating), 4 pairs of legs, unsegmented abdomen with spinnerets for silk.

Class Merostomata
Horseshoe crabs, large cephalothorax, has chelicerae, pedipalps, and legs, book gills, telson

Phylum Arthropoda
#1 most diverse phylum of animals, > 1 million named species, over half of the species are insects

Subphylum Cheliceriformes
ex: Horseshoe crabs and arachnids, cephalothorax and abdomen, on cephalothorax paired chelicerae (mouthparts), paired pedipalps (sensing, food manipulation, transfer of sperm)

Subphylum Myriapoda
ex: centipedes and millipedes, head and multisegmented trunk, head has 1 pair of antennae and paired mandibles, legs on trunk either 1 or 2 pairs per segment, appendages are unbranched, most have tracheal respiratory system with spiracles (to breathe).

Subphylum/Class Crustacea
ex: crabs, lobsters, barnacles, on cephalothorax, 2 pairs of antennae, paired mandibles, most have 5 pairs of chelate, pincher-like, appendages, abdomen has appendages called swimmerets. Appendages are biramous (two-branched)

Subphylum Hexapoda
ex: insects "6 feet", only one class "insecta" (LARGEST NUMBER OF DESCRIBED SPECIES), head, thorax, abdomen. Appendages are uniramous (unbranched). Most have tracheal respiratory system with spiracles.

Subphylum Myriapoda: Class Diplopoda
Millipedes (2 pairs of legs per segment)

Subphylum Myriapoda: Class Chilopoda
Centipedes, ( 1 pair of legs per trunk segment), venom claws on trunk segment nearest the head.

Phylum Echinodermata
Coelomate, Unsegmented, Pentamerous radial symmetry, water vascular system, dermal endoskeleton with spines that extend through skin.

Phylum Echinodermata - Class Asteroidea
Sea stars; starfish, 5 arms, madreporite, central disc where arms meet, mouth for feeding, tube feet for attachment

Madreporite
light-colored, distinct opening used to filter water in asteroidea

Phylum Echinodermata - Class Ophiuroidea
Brittle stars, 5 arms, central disc with sperentine arms

Phylum Echinodermata - Class Echinoidea
Sea urchins and sand dollars, mouth is called aristotle's lantern in sea urchins (has a jaw)

Phylum Echinodermata - Class Holothuroidea
Sea cucumbers, not sedentary just slow, tentacles at mouth, cloaca and vent at anus, radial muscles, alimentary canal (intestines) thick, gonads are thinner and orange, respiratory trees very thin and highly branched.

Tapeworm Structures

earthworm cross section

4 defining traits of phylum chordata
Dorsal, tubular nerve cord
Notochord
Pharyngeal gill slits
Postanal tail

Subphylum Urochordata
Chordata, tunicates (sea squirts)

Subphylum Cephalochordata
Chordata, lancelets and Amphioxus

Subphylum Vertebrata
Chordata, vertebrates

Class Agnatha
Chordata, Subphylum vertebrata, jawless fish (lampreys, hagfishes, etc.)

Class Chondrichthyes
Chordata, Subphylum vertebrata, cartilaginous fish (sharks, skates, rays)

Class Osteichthyes
Chordata, Subphylum vertebrata, bony fish with paired fins

Class Amphibia
Chordata, Subphylum vertebrata, two pairs of legs; smooth skin (frogs, salamanders, etc.)

Class Mammalia
Chordata, Subphylum vertebrata, hair, mammary glands, 2 paired appendages

Cyclostome
Jawless Vertebrate

Gnathostome
Jawed Vertebrate

Tympanum
Eardrum on frog

Paedomorphosis
Larval characteristics retained in adult

Plastron
Ventral plate on turtle

Carapace
Dorsal plate on turtle

Smooth muscle
not striated; single nucleus

Cardiac muscle
many striations; intercalated discs; 1 nucleus per cell

Skeletal muscle
many nuclei; many striations

Digastricus

Masseter

Biceps brachii

Triceps brachii

Pectoralis major

External oblique

Triceps femoris rat

Gracilis rat

Acromiotrapezius

Spinodeltoideus

Latissimus dorsi

Gluteus maximus

Gastrocnemius

Axial skeleton

Appendicular skeleton

Vertebrate

Femur

Fibula

Tibia

Patella

Phalanges

Clavicle

Scapula

Humerus

Radius

Ulna

Carpals

Metacarpals

Mandible

Blood smear labels
Erythrocytes
Red blood cells

rat reproductive system male

rat reproductive system female

cross section of mammalian testes

rat excretory system

kidney model
